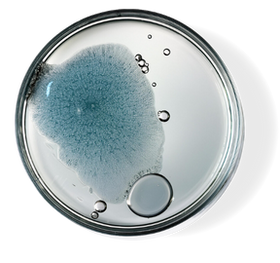

Aqua (Deionized Water), Kaolin Clay, Glycerin, Hydrogenated Ricinus Communis (Castor) Seed Oil, Cetearyl Alcohol, Ceteareth-20, C14-C22 Alkane, Glyceryl Stearate, PEG-100 Stearate, Magnesium Aluminum Silicate, Stearic Acid, Cetyl Alcohol, Magnesium Aspartate, Glycerin, Curcuma Longa (Turmeric) Root Extract, Crocus Sativus Meristem (Saffron Stem Cell) Extract, Snail Secretion Filtrate (Snail Mucin), Zinc Gluconate, Copper Gluconate, Oryza Sativa (Rice) Bran Extract, Rosmarinus Officinalis (Rosemary) Leaf Extract, Helianthus Annuus (Sunflower) Seed Extract, Hippophae Rhamnoides (Sea Buckthorn) Seed Oil, Tocopherols, Phenoxyethanol, Hexylene Glycol, Caprylyl Glycol, Ethylhexylglycerin.